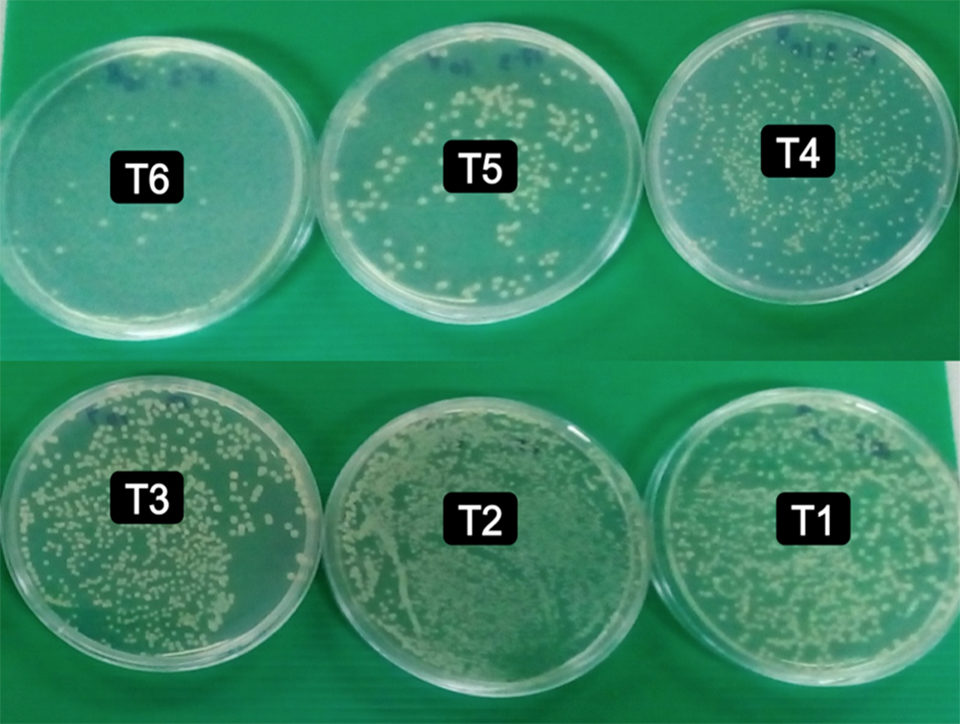

Results using Biotronic Top Liquid show improved growth, disease resistance

Cultured tilapia plays a significant and growing role in global seafood supplies. Increasing rapidly, annual global production is expected to be around 6.4 million metric tons (MMT) in 2017, and production has increased by 1 MMT every four years during the 15 years. Tilapias are considered to be generally disease resistant when grown in green water ponds, but cage culture has evolved as a better alternative to maximize production per unit volume of water.
However, with increased intensification of production there are frequent outbreaks of important diseases mainly due to overcrowding and periodic handling. Environmental factors such as sudden water temperature changes, inadequate water quality and nutrition can lead to stress or immunosuppression that contribute to infection by various pathogenic bacteria such as Aeromonas sp., Edwardsiella sp., Flavobacterium columnare, Pseudomonas fluorescens, Streptococcus sp., Vibrio anguillarum, and even a recently reported virus – Tilapia Lake Virus (TiLV). It is very difficult and impractical for tilapia culture systems to be totally free of these and other pathogens.
To manage some of these bacterial pathogens, various antibiotics and chemicals are sometimes used mixed in with aquafeeds. Their use can have negative effects – such as promoting antibiotic resistance and human and environmental hazards – so various other products have been and are being researched and tested as alternatives to antibiotics.
Biotronic® Top Liquid (BTL; BIOMIN Holding GmbH, Austria) is a combination of three organic acids alongside with the Biomin® Permeabilizing Complex (BPC). BPC disrupts and permeabilizes the outer wall of Gram-negative bacteria, increasing their sensitivity to the organic acids within the supplement mixture and increasing the synergistic effects of BTL constituents. The antimicrobial activity of BTL has been previously demonstrated against E. coli and Salmonella of both the Enteritidis and the Typhimurium serovar. BTL is commercially available and has been used in aquafeeds for shrimp and some fish species; however, few scientific studies have been published so far. In our research we investigated the effect of BTL against infection by Aeromonas hydrophila, as well as its effect on growth variables, in Nile tilapia fingerlings.
Experimental culture system and diets
Our experiment was conducted at the Aqua-Centre, Asian Institute of Technology (AIT), Thailand for a total of 12 weeks using monosex male Nile tilapia (Oreochromis niloticus) fingerlings from AIT’s own hatchery. The fish were acclimated for two weeks and fed 3x/daily with a control diet (22.9 ± 1.3 percent crude protein). Then, 18 fish were sampled for proximate analysis, and the remaining, acclimated fish (16.17 ± 0.40 g, mean ± SE) were distributed randomly at 45 fish each per 100 L, aerated aquarium. Uneaten food and feces were collected daily by siphoning. Fish were fed with the test diets twice daily at an initial feeding rate of 4 percent of biomass, which was then adjusted once biweekly. Water temperature in the aquaria (26.2 to 31.6 degrees-C), dissolved oxygen concentrations (3.87 to 5.96 mg/L), pH (6.8 to 7.6) and ammonia concentration (0.03 to 1.52 mg/L) were all within the acceptable ranges.
A total of 100 kg (20 kg/treatment) of feed was prepared using an available commercial feed (22.9 ± 1.3 percent crude protein), mixing in 0.0, 0.5, 1.0, 1.5, 2.0 and 2.5 L of BTL per ton of feed (T1-T6 respectively) and randomly allocating the diets (three replicates each) to 18 aquaria. After the diets were prepared, 1 kg was sampled for proximate analysis of protein, lipid, ash and fiber and BTL recovery.

Fish survival and growth during feeding trial
Fig. 1 shows the growth parameters resulting from the feeding experiment. Average fish survival ranged from 74.8 to 84.4 percent but the values were not significantly different (p > 0.05) among the treatments (dosages). However, fish biomass increased linearly (Fig. 1) with increasing BTL dosages. Improvements were also seen in specific growth (SGR) and daily weight gain (DWG) with increasing doses (Fig. 1). Biomass increased linearly, and feed conversion rate (FCR) and feed conversion efficiency (FCE) showed similar improvements.

Bacterial challenge test
After the 10-week feeding trial, a sample of 10 fish were randomly sampled from each of the 18 replicate aquaria for a bacterial challenge test using the bacterium Aeromonas hydrophila, which was isolated from infected Nile tilapia. Another set of 10 fish were maintained under normal conditions in aquaria without any bacterial challenge.
The water volume of each 30-L aquarium was adjusted to 10 L and stocked with 10 of these fish (50.4 ± 3.31 grams, mean weight ± SE), and challenged by immersion with A. hydrophila at 1 x 108 CFU. After three hours of this challenge, the water volume in each aquarium was increased to 30 L
Another set of 18 aquaria were subjected to the same protocol without bacteria and using only 0.85 percent (w/v) NaCl. Cumulative mortality and external observations of fish were noted daily for 14 days, and dead fish were recorded and removed. Data on the resulting survival are presented in Fig 2.

Average fish survival improved linearly with increasing supplementation doses (Fig. 3), showing an increase of almost 9 percent for every liter of BTL dose. We do not know if higher doses could have improved survival, but interestingly, survival of unchallenged fish remained high (> 90 percent) and there was no clear sign of improved survival in this group due to the supplementation (Fig 3). The weight/biomass gain increased by 81 percent (p < 0.05) over the control at the highest dose of BTL in the challenged group, whereas in the unchallenged group with the highest BTL dose the resulting biomass gain was only 42 percent higher than that of control group (Fig 4).

Specific growth rate (SGR), daily weight gain (DWG), protein efficiency ratio (PER) and overall food conversion efficiency (FCE) all increased with increasing BTL dose in both challenged and unchallenged fish (Fig. 4). The increase in average SGR per liter of BTL in the case of challenged fish was 0.3509 percent (Fig. 4), or 3.4 times higher than the SGR of unchallenged fish (0.1043, Fig. 4). Similarly, the average DWG of challenged fish was 1.6 times, PER 2.1 times and FCE 1.8 times higher than for unchallenged fish.

Clinical signs and blood composition
During the bacterial challenge, fish became lethargic after only three hours, and mortalities were observed after six to 12 hours. After the first day, feed intake had decreased and stress signs (darker coloration) were noticed; by the third day, signs of fin rot and hyperemia (blood congestion in parts of body) were observed. From days seven to 14, feed intake continued to decrease, and fish exhibited several signs of stress. We collected and analyzed blood samples from several fish, and observed a gradual decrease in the number of colonies and total bacterial count with increasing BTL levels from T1 to T6 (Fig. 5), as well as a significant difference (p < 0.05) in bacterial colonies between T6 and the control.
Discussion
During the first 10 weeks of the feeding trial, tilapia survival remained at 75 percent or higher and did not differ with BTL dose, indicating that the culture conditions and health of the fish remained within the comfort zone when BTL was applied at up to 2.5 L per ton of feed. However, linear increments in biomass and feed conversion efficiency, and also a linear decrease in FCR values also indicate that BTL addition promoted good responses in growth and feed utilization, and that further increases in the dose of BTL may increase these performance parameters up to a certain level.
In addition, BTL appeared to promote resistance in fish challenged with a disease-causing bacterium (A. hydrophila). Infection of this bacterium occur when predisposing factors are present, such as abrupt temperature changes and stress due to handling, crowding, and also inadequate feeds and oxygen.
We believe that applications of BTL as a preventive measure could be a promising, inexpensive, responsible and easy to use alternative to promote tilapia production. With public opinion and regulatory authorities in many importing countries – especially in the EU and the US – focusing now on the misuse of antibiotics in aquaculture, attention has shifted towards other methods to improve production. The EU has banned all antibiotic growth promoters (AGP) from livestock production, since the use of low levels of these antibiotics in animal feeds increases the bacterial resistance on species pathogenic for animals but also for humans. It is expected that more countries will follow the same policy, and in the case of Asian countries exporting to the EU, they will need to comply with these standards.

Perspectives
Our study showed that BTL enhances growth, feed conversion efficiency and protein efficiency ratio, and reduces feed conversion ratio when used at doses higher than 1.5 L/ton. Its effects are more prominent in the presence of bacteria, especially A. hydrophila at higher doses, i.e., over 1 L/ton of feed, and up to 2.5 L per ton. The trend indicates that higher doses could be beneficial for growth; however, more research is needed to confirm that. At the same time, whether increased growth can be cost-effective beyond the level of 2.5 L/ton needs to be confirmed.
Because BTL inclusion in feed showed positive impacts on the growth and overall performance of Nile tilapia fingerlings, especially when exposed to A. hydrophila, we can recommend it for supplementation up to the maximum tested level of 2.5 L/ton. Further research is needed to test the product under different conditions, animal sizes and actual farm conditions. But we believe, based on our test results, that BTL is a promising alternative to antibiotics in fish aquafeeds, although more research is needed in other species.
References available from first author.
Now that you've reached the end of the article ...
… please consider supporting GSA’s mission to advance responsible seafood practices through education, advocacy and third-party assurances. The Advocate aims to document the evolution of responsible seafood practices and share the expansive knowledge of our vast network of contributors.
By becoming a Global Seafood Alliance member, you’re ensuring that all of the pre-competitive work we do through member benefits, resources and events can continue. Individual membership costs just $50 a year.
Not a GSA member? Join us.
Authors
-
Ram C. Bhujel, Ph.D.
Aqua-Centre, School of Environment, Resources and Development (SERD)
Asian Institute of Technology (AIT), Thailand[97,105,115,97,46,116,105,97,64,108,101,106,117,104,98]
-
Anusha Perera, M.Sc.
Aqua-Centre, School of Environment, Resources and Development (SERD)
Asian Institute of Technology (AIT), Thailand -
Rui A. Gonçalves, M.Sc.
BIOMIN Holding GmbH
Erber Campus
13131 Getzersdorf, Austria[116,101,110,46,110,105,109,111,105,98,64,115,101,118,108,97,99,110,111,103,46,105,117,114]
Tagged With
Related Posts

Aquafeeds
A look at phospholipids in aquafeeds
Phospholipids are the major constituents of cell membranes and are vital to the normal function of every cell and organ. The inclusion of phospholipids in aquafeeds ensures increased growth, better survival and stress resistance, and prevention of skeletal deformities of larval and juvenile stages of fish and shellfish species.

Aquafeeds
A look at protease enzymes in crustacean nutrition
Food digestion involves digestive enzymes to break down polymeric macromolecules and facilitate nutrient absorption. Enzyme supplementation in aquafeeds is a major alternative to improve feed quality and nutrient digestibility, gut health, compensate digestive enzymes when needed, and may also improve immune responses.

Aquafeeds
A look at the SME controlled extrusion process
A study was conducted using a Twin-Screw Extruder equipped with Specific Mechanical Energy (SME) and Density Control valves, to determine the effect of SME on the water stability of shrimp feeds. Further research is needed to evaluate the performance.

Aquafeeds
Analyzing the hydrostability of shrimp feeds
The physical integrity and nutrient leaching of shrimp aquafeeds are important aspects in their quality control. The water stability of shrimp aquafeeds is often evaluated in various subjective manners. This analytical procedure provides a baseline for the aquafeed manufacturer to assess product quality.



